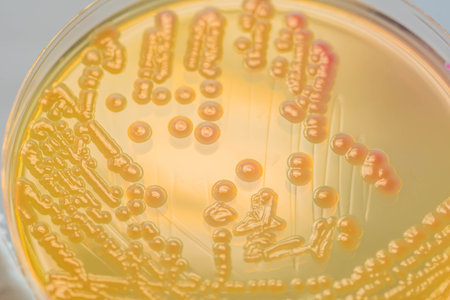
Bacterial colonies culture on MacConkey agar media contains small light grains. Focus on all agar surface. の写真素材

写真素材 - Bacterial colonies culture on MacConkey agar media contains small light grains. Focus on all agar surface.
作品情報
Bacterial colonies culture on MacConkey agar media contains small light grains. Focus on all agar surface.
- ID:99216443
- 作品種別:写真
- 作者名:Sirirat Makprasert
キーワード
- Media
- agar
- air
- aureus
- background
- bacteria
- bacterial
- bacterium
- biology
- biotechnology
- black
- blood
- cabondioxcine
- cell
- colony
- color
- culture
- danger
- dish
- growth
- health
- healthcare
- hygiene
- isolated
- lab
- laboratory
- medical
- medicine
- medium
- micro
- microbe
- microbiology
- oxidase
- pathogen
- pathogens
- petri
- plate
- plates
- red
- research
- risk
- safety
- science
- scientific
- streak
- test
- treat
- yellow
類似作品
Backgrounds of ...
Bacterial cultu...
Laboratory tech...
some pearls wit...
Abstract ink te...
Bacteria growin...
Backgrounds of ...
Gloved hands of...
Escherichia col...
Close up the me...
Backgrounds of ...
Backgrounds of ...
Backgrounds of ...
Petri dish with...
Backgrounds of ...
Study Colony ch...
Backgrounds of ...
Texture of natu...
Modern Healthca...
Backgrounds of ...
Backgrounds of ...
E. coli growing...
Abstract brown ...
Colonies of bac...
Collection of P...
Beautiful acryl...
Backgrounds of ...
Mushroom cultiv...
A hand in dispo...
Bacterial cultu...
different sampl...
Yeast in petri ...
microbiology la...
Bacterial colon...
Various colorfu...
E coli bacteria...
red colony in p...
Helicobacter py...
Colonies of bac...
Characteristics...
The real coloni...
Antimicrobial s...
Foos safety pat...
Agar plate with...
chemist wearing...
Bacterial colon...
Colonies of Gra...
A researcher in...
Bacterial cultu...